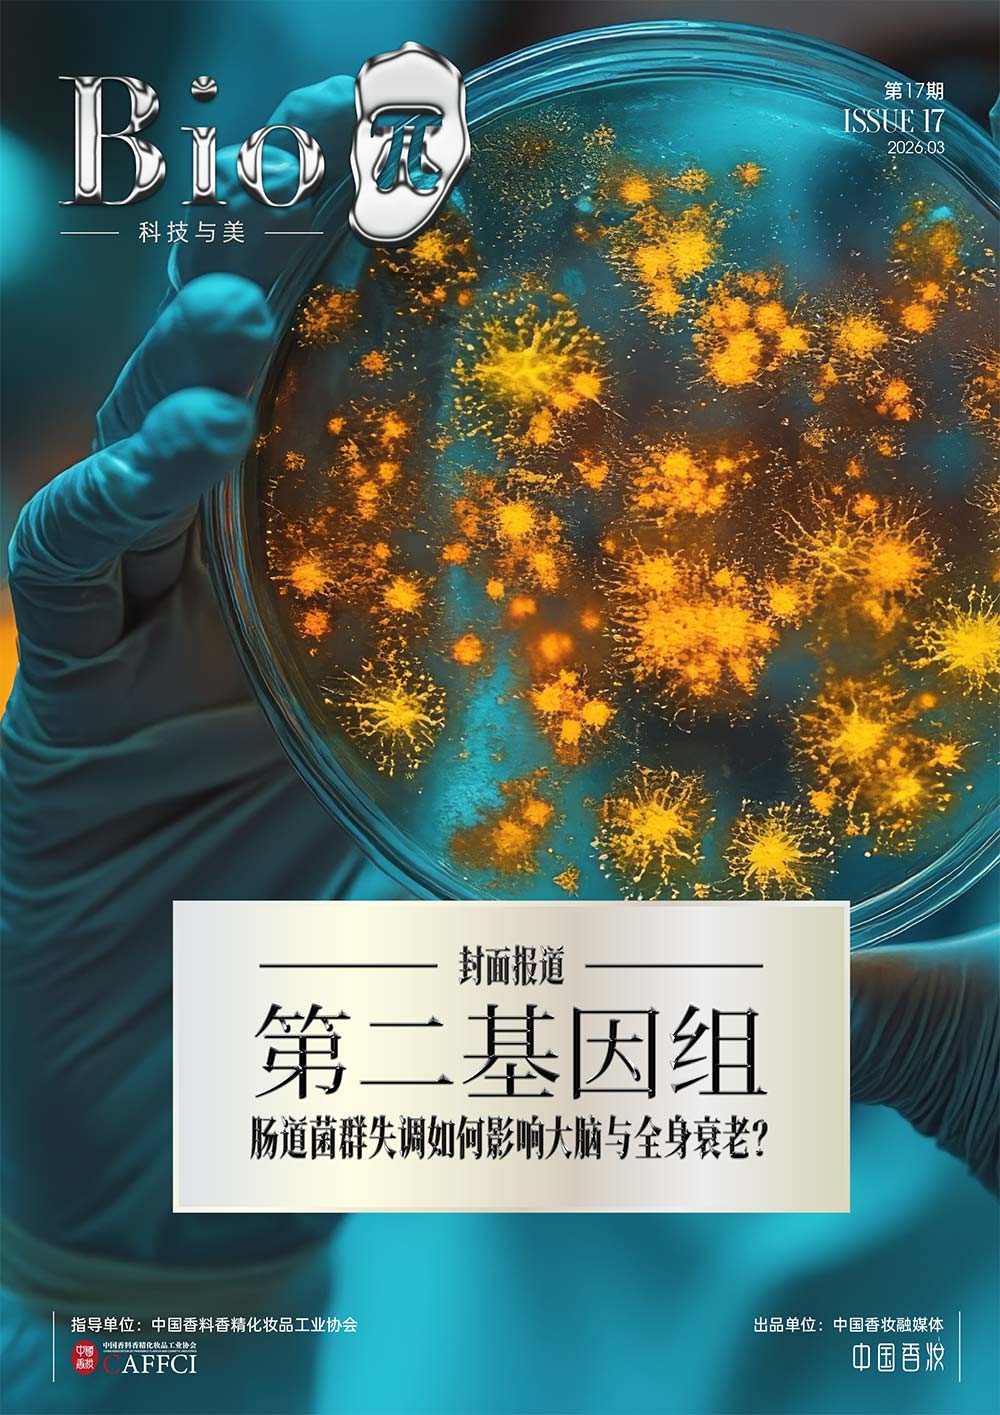

特别报道
“十五五”系列
以“质”致远:中国香妆行业迈入“十五五”高质量发展新征程
2026年03月15日 10:26
2026年,是“十五五”规划的开局之年。同时,随着今年全国“两会”的召开,宏观政策的定调、经济工作的部署、产业发展的方向都将清晰明朗。对于正处于从“制妆大国”向“制妆强国”跨越关键期的中国香妆产业而言,这一历史时刻的意义尤为深远。
其中,作为万亿级消费市场的产业,中国化妆品行业不仅承载着消费升级的使命,更在政策红利与自身变革的双重驱动下,迎来了量质齐飞的新阶段。站在“十五五”的起点上,我们有必要重新审视这个行业的成长逻辑、结构变化与未来走向。

“十五五”开局之年的经济政策基调,依然是稳中求进、以进促稳。与以往不同的是,2026年的政策重点将更加精准、更具系统性。去年中央经济工作会议明确提出“大力提振消费”“以科技创新引领新质生产力发展”,为香妆产业的高质量发展指明了方向。
对于消费型产业而言,政策红利不再只是简单的需求刺激,而是更深层次的供给端改革与监管优化并举。一方面,减税降费、优化营商环境,为企业减负;另一方面,高标准市场体系的构建,为高质量产品“增信”。特别是在平台经济、直播电商等新业态的规范治理逐步常态化的背景下,政策致力于清除“劣币驱逐良币”的土壤,为坚守长期主义的企业营造可预期的宏观环境。
这种“放管结合”的政策思路,本质上是在用政策的确定性对冲市场的不确定性,为实体经济注入信心与动力。


政策的春风,最终要落地到产业的沃土之中。中国香妆协会近日发布的数据显示,2025年中国化妆品全渠道交易额突破1.1万亿元,达到11042.45亿元,同比增长2.83%。连续三年站稳万亿台阶,背后是产业结构的深刻质变。
更值得关注的是国货品牌的市场表现。数据显示,国货品牌的市场份额已提升至57.37%,正式确立市场主导地位。这不仅是消费自信的体现,更是东方美学与现代科技融合的结果。同时业内折射出消费观念的成熟与产业能力的提升。
在技术层面,原料创新的突破尤为亮眼。2025年,化妆品新原料备案数量再创高。原料被称为化妆品的“芯片”,这一跃升意味着中国化妆品行业正在摆脱对国际原料商的依赖,逐步掌握创新的主动权。
去年11月,国家药监局发布《关于深化化妆品监管改革促进产业高质量发展的意见》,提出24项改革措施,堪称献给“十五五”开局之年的政策大礼。其中,“畅通新功效化妆品注册渠道”“鼓励国际化妆品新品在中国首发”“促进化妆品银发经济发展”等举措,精准切中行业痛点。可以预见,随着科学监管政策在2026年落地深化,监管与创新将形成双向奔赴的合力,监管的终极目的不是限制,而是护航发展。


当我们从宏观转向微观,便能更清晰地看到中国香妆企业正在发生的深刻变革。这种变革,体现在三个层面的逻辑重构。
首先是竞争逻辑的重构。过去依赖流量驱动的粗放式打法正在被淘汰,行业进入供给侧结构性调整期。2025年,淘汰品牌数量达2.69万个,占总活跃品牌的41.08%。这场看似残酷的洗牌,实则是市场的自我净化。资源加速向具备科技含量和品牌底蕴的头部企业集中,排名前500的品牌中超60%保持正向增长。良币驱逐劣币,正是一个产业迈向成熟的标志。
其次是生产逻辑的重塑。随着《化妆品企业生产质量管理体系提升三年行动计划(2026-2028年)》的印发,2026年成为夯实质量根基的关键一年。计划提出,到2028年底培育至少50个可复制推广的典型经验,推行“一企一策”“服务到企”。这意味着,合规不再是企业的成本负担,而成为核心竞争力的护城河。当全行业从拼营销转向拼体系、拼管理,高质量发展的微观基础便得以确立。
再者是消费逻辑的演进。理性消费时代,消费者不再为虚高的品牌溢价买单,而是愿为扎实的成分和切实的功效付费。这种消费观的变迁,倒逼企业在科技研发上做加法,在流量模式上做减法,成为产业高质量发展的内生动力。
总之,站在“十五五”的开局起点,回望过去五年,中国香妆产业用时间完成了从规模扩张到质量觉醒的蜕变。从政策引导到产业响应,从消费升级到技术创新,行业的每一个环节都在经历深刻的重构。未来已来,唯变不变。在宏观政策的暖阳下,在万亿级市场的沃土上,中国香妆产业正以“质”致远,迈向下一个高质量发展的黄金周期。我们有理由相信,在“十五五”期间,这个行业将以更加自信的姿态,书写属于中国的“美丽健康产业经济”新篇章。
本文为特约评论员文章,作者江湖散人,财经作家、前媒体人。Bioπ中国美肤科学传播平台发布本文只是为了传递更多的讯息,不代表任何有倾向性的投资意见或市场暗示,仅供行业参考。
THE END

京公网安备11010502058609号